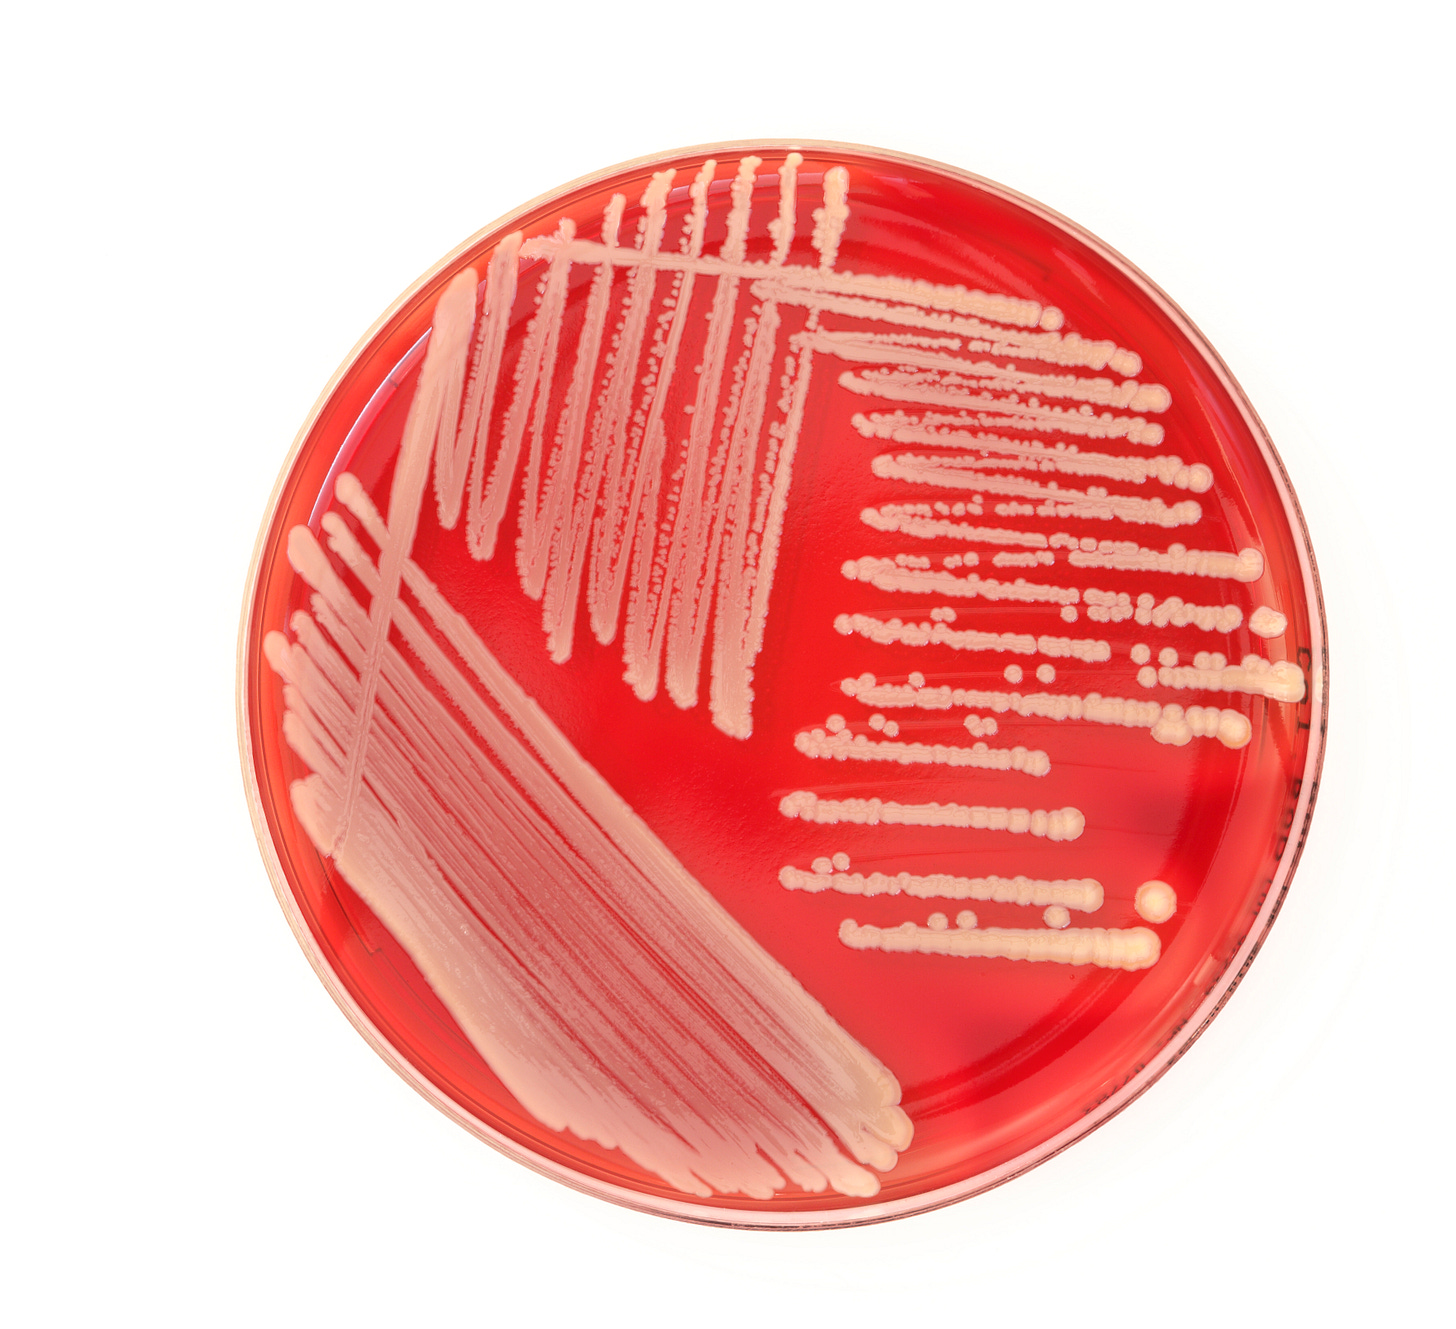

Every edition features 7 stories, from the past week. I’ll draw on my background in media, journalism, agriculture, biotech, and renewable energy to come up with an interesting selection and to offer some context.
My dad made it to 100 years before he passed away and a friend of his marked her 101st trip around the sun this week. How long can we hang on makes the top of the list for this edition of 1 Week, 7 Stories.
The New York Times this week raised the question of whether we have reached “peak human life span”. Improved medical care and better awareness of lifestyle factors has helped more people live into their 70s, 80s, and 90s, but don’t expect to see advances that will help you break the verified record of Jeannne Calment who died aged 122. ( Some dispute her story which is nicely outlined in this feature from the New Yorker.)
A study published this week in Nature Aging found that after a period of acceleration in average life expectancy, we are now decelerating. The researchers say that “radical human life extension is implausible in this century”. However, given that 34 years was a good bet in 1800, and about 68 years in 1950, your 5% to 15% chance of making it past 100 today is still significant. In Canada the life expectancy has fallen 3 years in a row and currently sits at 81.3 according to the Stats Canada Deaths,2022 report.
The study on our “peak” life span focused on the numbers from around the world, but inevitably there are biological limits. We are not built to keep going and going. You are aging from the moment you are born and as long as we grow faster than our parts break down, we are doing fine. Eventually cell damage outpaces our body’s mechanisms to repair that damage. Genetics plays a part in the aging process and unfortunately so do socioeconomic conditions. The 10% of top income earners in the US and the UK live more than a decade longer than the bottom 10%.
There are of course more philosophical questions about why we die at all or why we do not at least live longer. It is just they way things are.
Had a shower and brushed your teeth yet today? If not, better save this story until later.
A new study published this week in Frontiers in Microbiomes says that showerheads and toothbrushes have their own microbial community with more than 600 different viruses. The media release from Northwestern University calls it “awe-inspiring biodiversity” in your bathroom.
Fortunately, you don’t have to put on your hazmat suit because the microorganisms are bacteriophages which infect bacteria – not people. More commonly known as phages these viruses reproduce inside bacteria cells which eventually kills it. They are one of the newest lines of defence in dealing with our current efforts to find improved alternatives to kill off disease causing microorganisms that have become drug resistant. Just this week researchers at the University of Chicago published a study on what amounts to a phage cocktail which is effective in killing off a form of pneumonia.
The population of viruses from your showerhead and toothbrush included many that had received little attention and others which had never been seen before. Much too early to tell if the new ones can be enlisted to help deal with antibiotic-resistant bugs. In the meantime, the researchers say not to attack your bathroom with strong disinfectants as this simply adds to the resistance problems. Instead, vinegar or plain soap and water for the showerhead and replacing your toothbrush more often is all you need to do.

In 1914, Ernest Shackleton set out to lead his Imperial Trans Antarctic Expedition on a trek to make the first land crossing of the Antarctic. He left London in November of 1914 and after a brief stop at the whaling station on South Georgia Island, his ship the Endurance hit pack ice. By January of 1915 it was trapped in the ice. On October 27th the ship was being crushed by the ice, so he and the crew abandoned the vessel and let it sink in 3,000 metres (9800 feet) of water. They were still 160 kilometres (100 miles) from land. The crew survived and were all eventually rescued.
This week a video of the sunken ship was released in advance of the screening of a documentary called Endurance which will soon be released in theatres and later on Disney+. The digital video was made from 25,000 hi-res images of the ship taken when it was finally found in 2022. The footage (which belongs to the Falklands Maritime Heritage Trust) is incredibly detailed and as this BBC story points out includes clear images of the food plates the crew members used, and a flare gun sitting on the deck where the diary of Frank Hurley, the expedition’s photographer, said it would be.
Shackleton would be at home here in the 21st century because he used the latest in technology to document the voyage with photographs and 35-millimeter film kept safe and intact by Hurley. Some of that material is included in the documentary.
With WWI limiting any further exploration Sir Ernest Shackleton could not make another journey to the Antarctic until 1921. Once again, he died not reach his goal because he died of a heart attack while his ship was moored in South Georgia. He was buried in the cemetery there.
Earlier this month Mexico’s new president was sworn in which could prove to be a problem for US corn exports. Specifically corn which has been bioengineered for targeted traits such as pest and disease resistance and tolerance to certain pesticides to help farmers manage weeds.
About 90% of US corn is classified as genetically engineered and until 2023 Mexico was the largest importer of American corn worth $5.4 billion USD. When the previous president of Mexico López Obrador was elected in 2019 he promised to encourage agroecological practices, phase-out the import of genetically modified(GM) corn and ban the use of GM corn in flour and tortillas. There was hope in the US that the election would push back the ban, but President Claudia Sheinbaum has vowed to follow through on restricting imports.
The US has challenged the ban under the US-Mexico-Canada Agreement (USMCA) on the grounds that it is not backed by scientific evidence. A formal dispute panel was established and in June of this year the 2 countries presented oral arguments to the panel and a decision is expected in November. Under the USMCA there is an appeal process.
A bipartisan group of US lawmakers led by Randy Feenstra (R-Iowa) is eager to see the ban lifted and says it should have been resolved when the USMCA was being negotiated.
Studies have show that genetically modified crops are safe to eat and when it comes to the biotech corn, the USDA has approved it for human consumption.
How this dispute plays out will likely be significant. The US agricultural sector will feel the loss of a major export if the panel rules in favour of Mexico, crop planting decisions will be revised, and depending on who is sitting in the White House come 2025, there could be trade retaliation.
-
How often have you heard it? You look just like your father. Or mother. Or any other member of your family from siblings to cousins. Often for good reason too, because there is a strong connection between how you look and your genetics. There are 32 gene regions (nose, lip, jaw, etc) and hundreds of genes involved in making you look like you, and perhaps like someone else. Add in environmental factors and it becomes all the more complex and amazing that family similarity manages to emerge at all. As children are growing up, nutrition can make a difference as can exposure to certain environmental toxins during pregnancy. How it all comes together is not yet fully understood, but we are getting there.
For instance, researchers from the University of Pittsburgh scanned the DNA of 8,000 people to see how genetics relates to facial features. That research found that your nose was the most likely to be affected by genetics and your cheeks are the least likely to be influenced by genes but are more susceptible to lifestyle factors.
Work being done by Benedikt Hallgrímsson at the University of Calgary has taken the link between facial features and genetics to an even higher level. In collaboration with researchers from the University of Colorado and UC San Francisco, Hallgrímsson is using 3D facial scans and machine learning to improve diagnoses for children with rare genetic diseases. That work began in 2020, but 3D scanning technology has developed quickly. In a YouTube video from the U of C this week, the once cumbersome machine is now a 1.65 x 1.65 metre (5 by 5 foot) instant tool. The 3D scan technique has proved to be highly effective in recognizing 396 different syndromes of the thousands that affect craniofacial features.
Not bad for a field of study that likely began with, “you look just like…”
-
In 1990 Perrier announced a total recall of its bottled water in 120 countries when benzene turned up in samples in Canada, the Netherlands, and Denmark. The company said that it was naturally occurring benzene that was not properly filtered before bottling. It survived that setback and has become a billion-dollar brand now owned by Nestlé SA.
The Perrier waters are becoming murky again with fecal contamination at one of its wells and traces of pesticides banned in France 20 years ago. The bottled water industry is worth about €1 billion ($1.5 billion Cdn) in exports to France and employs 38,000 people.
The latest problems for Perrier are raising questions about bottled water in general. The pesticide contamination is occurring at the source of the water in deep wells and the fecal contamination is caused in part because of torrential rains which have become more frequent and more intense.
Most bottled water (including Perrier) has been filtered in some manner which begs the question of why bottles of water are shipped from France to land on your local grocery shelf. Why not get locally filtered water? Better yet, why bottled water at all?
The cost of the water in the bottle is the smallest portion of what you pay. The rest are markups on packaging, marketing, shipping, and of course the bottle itself. Some estimates say that just to make the plastic bottle it takes 3 or 4 times the amount of water than what is in the bottle and uses the equivalent of one-quarter of a bottle of oil to make and transport your single bottle of water. Then there are the 240,000 particles of nanoplastics that come with the thirst-quencher you picked up at the convenience store. Not to be overlooked is the depletion of groundwater to fill the bottle which eventually has to be disposed of. Multiply that by the 2 billion bottles of water Canadians chug back every year.
A whole let easier on the pocketbook and the environment if we just turn on the tap at home. Judging by the challenges facing the industry in France, probably safer as well.
-
A new article in Nature Climate Action argues that a scientist is not a “brain in a jar” who should be arms-length from social and political entanglement. The article was largely in response to an earlier article in the same journal that said scientists (in particular climate scientists) should not have an interest in the outcome of their studies.
Both make a pretty good case in a discussion that is especially relevant when we are surrounded by misinformation, bad information, and online havens where we can retreat into groups that share are views. It becomes even more important when science and scientists are tackling extreme problems ranging from diminishing resources, environmental threats, pandemics, and changes to our climate.
This post from the Dutch Research Council suggests that not only is there no clear boundary between science and activism, but that as soon as scientists share their knowledge, they have begun to exert influence. Climate science in particular blurs that line because many of its studies and conclusions make it into the public and political debate. Media, podcasters, and bloggers turn to scientists for some expert opinion which puts them in the spotlight. A 2022 study (but published in 2024) found that researchers who got involved in climate crises protests did not take a hit to their academic credibility.
An article in Royal Society Open Science points out that understanding the current climate crisis relies on science and goes in to make the case that scientists can and should become agents of change.
Leave a comment and tell me what you think the boundaries are or should be.
Read, comment, subscribe, and share this newsletter.
I’m available for contract and freelance work with not-for-profits and charities. With 40 years of experience behind me and lots of time ahead of me, I’m here to help you make a difference in your media relations, public relations, and general communications needs.